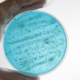

Can Schematic Drawings Reduce Legionella Risk?

Schematic drawings are often overlooked when it comes to managing the risks posed by Legionella bacteria, yet they play a central role in any robust water safety plan. By providing a clear, simplified picture of how a water system is designed and operates, these drawings help Duty Holders, the Responsible Person and Water Safety Groups to quickly identify risk areas such as dead legs, little-used outlets, and temperature control issues that could otherwise go unnoticed.
In this article we explore the role of schematic drawings in Legionella risk management, explaining what they are, why they matter, and how they should be created and maintained. We’ll also look at the standards and guidance that apply, consider how schematics support risk assessments and routine monitoring, and highlight why keeping them accurate and up to date is essential for effective Legionella control.
A version of this article asking “Can Schematic Drawings Reduce Legionella Risk?” first appeared in Legionella Control International’s newsletter. To get it in your inbox, sign up here.
The role of schematic drawings in managing Legionella
Those in charge of the safe management of water systems must be aware of all the risk factors that are present which may cause Legionella and other dangerous bacteria to multiply and spread throughout the systems under their control. It is vital to ensure those risks are identified, then removed or at least mitigated as much as is practicable.
One thing that isn’t often mentioned is the role that schematic drawings play in this process. Yet they are one of the most crucial aspects of a water safety plan. They can provide guidance and insight in many scenarios. Here, we’ll look at what these schematics are and how you can ensure you are using them correctly.
What are schematic drawings in relation to a water system?
A schematic drawing for water safety and Legionella control is a simplified diagram of a building’s water system that highlights key components and flow paths to identify risk areas and support effective management. They don’t include every minor detail but do provide insight into how the system works and highlight all the major components involved.
If you search online for schematics, you’ll probably come up with plenty of complex drawings that make no sense to you. This can happen, but in the case of water safety and the management of Legionella and other waterborne bacteria, all schematics must be readable by those responsible for the control of Legionella including those in the Water Safety Group.
Indeed, BS8580-1 2019 Annex G notes that schematics should be accurate but should also be ‘simplified illustrations’ of a water system. The document makes a comparison with an underground railway, explaining that they should make the layout clear enough for everyone to understand. Think of the London Underground map as an example, it is a highly simplified version of where the lines run from and to, and where they intersect. A schematic for a water system should run along similar lines, so that the Responsible Person and everyone in the Water Safety Group should be able to understand it. There should be no need for anyone to possess any specialist knowledge in this instance.
Schematics should also highlight all parts of the system, regardless of whether they are in use or not. Most importantly, they should also be fully up to date, to ensure they accurately reflect the water system as it is at present. Only then will it be useful when planning the management and maintenance of a water system.

Do you need schematics for a Legionella risk assessment?
Yes – if you are responsible for water safety in a business or organisation, you must have accurate and up to date schematic drawings that highlight all aspects of the water system. This is a requirement by the Health and Safety Executive (HSE), so if you are ever required to present these schematics, you must be able to do so without delay.
If you do not yet possess a set of schematics, it is usually best to hire the services of an external and experienced provider. They will know what is required and the standard that should be provided when creating a set of schematics to use for this purpose.
Furthermore, you should hire someone with experience in generating schematics for the building you are responsible for managing. A small location with a simple water system would not need to include a great amount of detail in its schematics. In contrast, a large hospital complex or other healthcare location would require far more detailed schematics to ensure that everything was included that needed to be.
How do schematics help manage Legionella risks?
No doubt you are aware of the importance of a Legionella risk assessment. The schematics can play a key role in this assessment. It’s possible to review the schematics before the assessment begins, to consider where any potential risk factors might be.
They also help you work out the layout and format of the water system and its various parts before you physically walk around and consider all the possible risks that are present. For example, you might spot one or two areas of pipework on the drawings that you know are no longer used, or perhaps are only infrequently used. These will be essential to cover in the risk assessment.
The ideal scenario would be to remove the dead ends or dead legs if they are redundant. However, in some cases this may not be possible, for example, there could be areas that rarely get used, but still need to be in place for those rare occasions.
In this example, you would highlight regular cleaning and flushing processes as the ideal solution. The schematics would help you pinpoint problem areas such as these, so you can make sure you physically check them out during a risk assessment.
These schematics also help when it comes to working out how to clean and maintain a water system. For instance, you may develop a plan to regularly clean and maintain certain parts of the system, going through those parts in turn to ensure everything is working properly and is kept clean.
You can also identify the outlets to use when monitoring the water temperature, as these are likely to change over time. The same applies for Legionella sampling. Where will you take water samples from? Which outlets should be used for this purpose, and how often should this be done?

Keeping schematic drawings up to date
Of course, schematics are one thing, updated schematics are the aim here. It’s not enough to generate a set of drawings that are accurate at that time, and then to tuck them away and forget about them. They should inform the risk assessment, the water testing, maintenance, and cleaning that goes on throughout the water system in question.
If any changes are made to the system, which could be a length of pipework being removed, a new tap installed, or a boiler being replaced, these should be noted on the schematics, with changes being made accordingly. This will ensure the schematics can always be relied upon when redoing a risk assessment or considering whether the water management processes are suitable and appropriate for the system in use.
Recognising the importance of schematic drawings
Accurate schematic drawings are far more than just a formality; they are an essential tool in identifying risks and maintaining safe, well-managed water systems. By keeping them clear, up to date, and integrated into your water safety planning, you can make the process of spotting and controlling potential Legionella hazards far more effective. As we’ve seen, schematics give everyone involved, from the Responsible Person to the wider Water Safety Group the insight they need to manage systems confidently and proactively.
Leading water safety specialists
At Legionella Control International, our specialists work with organisations across all sectors to create and maintain effective water safety strategies, including the preparation of accurate schematic drawings tailored to each site. If you’d like expert support in assessing your current schematics, updating them to reflect system changes, or ensuring they meet regulatory expectations, our team is here to help.
To discuss your requirements with one of our water safety experts, call us today on 0330 223 36 86.